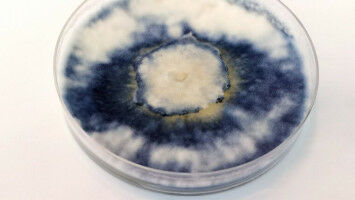
Blauer Pilz in neuem Licht

news
Friedrich-Schiller-Universität Jena
Ergebnisse 121 - 140 von 307.
Physik - 10.03.2023

Studienleiter Ulf Peschel und sein Team berichten im Magazin "Science", dass die Ausbreitung optischer Pulse durch eine Glasfaser den Regeln der Thermodynamik folgt. In der heutigen Gesellschaft werden täglich riesige Mengen von Daten Übertragen - meist in Form optischer Pulse, die durch Glasfasern geleitet werden.
Gesundheit - Biowissenschaften - 09.03.2023

Der krankheitserregende Pilz Aspergillus fumigatus entgeht seiner Vernichtung in Oberflächenzellen der menschlichen Lunge, indem er ein menschliches Protein bindet. Dadurch nistet er sich in abgegrenzten Bereichen - den Phagosomen - in den Lungenzellen ein. So verhindert der Pilz, dass Zellprozesse in Gang gesetzt werden, die ihn abtöten würden.
Biowissenschaften - Gesundheit - 03.03.2023

Bei einer autoimmunen Enzephalitis, einer seltenen, aber schwerwiegenden und mitunter lebensbedrohlichen Entzündung des zentralen Nervensystems, richtet sich die körpereigene Abwehr gegen das zentrale Nervensystem. Zum ersten Mal beschrieben wurde diese Krankheit im Jahr 2007. Am häufigsten tritt die anti-NMDA-Rezeptor-Enzephalitis auf.
Agronomie & Lebensmittelingenieur - Umwelt - 09.02.2023

In Jägerund Sammlergesellschaften bilden bereits Kinder geschlechtsspezifische Fähigkeiten zur Nahrungssuche aus, um besondere Nahrung verfügbar zu machen. Diese Errungenschaft sowie das Teilen von Nahrung könnte es der menschlichen Spezies ermöglicht haben, ein wesentlich größeres Gehirn zu entwickeln als unsere nächsten lebenden Verwandten.
Agronomie & Lebensmittelingenieur - Umwelt - 09.02.2023

In Jägerund Sammlergesellschaften bilden bereits Kinder geschlechtsspezifische Fähigkeiten zur Nahrungssuche aus, um besondere Nahrung verfügbar zu machen. Diese Errungenschaft sowie das Teilen von Nahrung könnte es der menschlichen Spezies ermöglicht haben, ein wesentlich größeres Gehirn zu entwickeln als unsere nächsten lebenden Verwandten.
Geowissenschaften - Physik - 07.02.2023

Zum ersten Mal haben Forscher live verfolgt, was bei einem Asteroideneinschlag in dem getroffenen Material genau vor sich geht. Das Team von Falko Langenhorst von der Universität Jena und Hanns-Peter Liermann von DESY hat dazu einen Asteroideneinschlag mit Quarz im Labor nachgestellt und quasi in Zeitlupe in einer Hochdruckzelle ablaufen lassen.
Biowissenschaften - Gesundheit - 06.02.2023

Bakterien der Gattung Pseudomonas produzieren einen stark antimikrobiellen Naturstoff. Das haben Forschende des Leibniz-Instituts für Naturstoff-Forschung und Infektionsbiologie (Leibniz-HKI) und die Universität Jena entdeckt. Sie wiesen nach, dass die Substanz sowohl gegen pflanzliche Pilzkrankheiten als auch gegen human-pathogene Pilze wirkt.
Umwelt - Biowissenschaften - 01.02.2023

Die Zahl der Insekten geht in den vergangenen Jahrzehnten in vielen Teilen der Welt zurück. Schutzgebiete könnten einen wesentlichen Beitrag zum Schutz bedrohter Insektenarten leisten, doch Forschende unter Leitung des Deutschen Zentrums für integrative Biodiversitätsforschung (iDiv), der Friedrich-Schiller-Universität Jena, des Helmholtz-Zentrums für Umweltforschung (UFZ) und der Universität Queensland fanden jetzt heraus, dass 76 Prozent der erfassten Insektenarten weltweit nicht ausreichend durch Schutzgebiete abgedeckt sind.
Informatik - Forschungsmanagement - 31.01.2023

Life Wissenstransfer & Innovation Meldung vom: Die Software JIPipe wurde von Wissenschaftlern am Leibniz-Institut für Naturstoff-Forschung und Infektionsbiologie (Leibniz-HKI) und der Universität Jena entwickelt und vereinfacht die Analyse von in der Forschung entstandenen Bildern entscheidend. Mit ihr können alle Interessierten nach ihrem Anwendungsbedarf Flowcharts erstellen und so ohne Programmierkenntnisse automatische Bildanalysen mithilfe künstlicher Intelligenz durchführen.
Biowissenschaften - 25.01.2023

Einem internationalen Forschungsteam ist es gelungen, eines der Rätsel der Evolution zu lösen. Die Wissenschaftlerinnen und Wissenschaftler gingen der Frage nach, weshalb sich der Lebenszyklus von Tierarten deutlich voneinander unterscheidet. Speziell ging es um die Frage, weshalb vor allem wirbellose Tiere während ihrer Individualentwicklung ein Larvenstadium durchlaufen.
Physik - 12.01.2023

Einem internationalen Team aus Forschenden, darunter auch Wissenschaftler aus Jena, ist es gelungen, eine neue und besonders präzise Art der Messung in winzigen Quantensystemen zu entwickeln. Anwendungen sind etwa in der Halbleiter-Fertigung, perspektivisch aber auch der Mobilfunktechnik oder Mikroskopie denkbar.
Gesundheit - Pharmakologie - 06.01.2023

Chronisch-entzündliche Prozesse sind die häufigsten Ursachen einer Vielzahl von weit verbreiteten Erkrankungen. So spielen sie bei Arthritis, Asthma, Parkinson und Alzheimer eine Rolle, aber auch bei Arteriosklerose, Diabetes und Krebs. Medikamente, die Entzündungen hemmen, gehören daher zu den am häufigsten eingenommenen Arzneistoffen weltweit.
Biowissenschaften - 14.12.2022

Forschende des Exzellenzclusters ,,Balance of the Microverse" und der Universität Jena konnten einen RNA-Schwamm identifizieren, der die Dynamiken des Quorum Sensing und der damit einhergehenden Bildung von Biofilmen beim Bakterium Vibrio cholerae kontrolliert. Cholerabakterien bilden erst ab einer gewissen Zelldichte, die sie mittels Quorum Sensing ermitteln, den krankheitsverursachenden Biofilm.
Physik - Informatik - 23.11.2022

Doktorand Christian T. Plass betrachtet eine Probe mit einzelnen Nanodrähten auf einer dünnen Schicht Siliziumdioxid auf Silizium. Zu erkennen ist nur das Substrat, da die Nanodrähte zu winzig sind. Ein Team der Friedrich-Schiller-Universität Jena hat eine neue Kamera, die ultraschnelle Prozesse zeitaufgelöst misst, an der Röntgen-Nanosonde ,,ID16B" des europäischen Synchrotrons ESRF in Grenoble (Frankreich) installiert.
Gesundheit - Pharmakologie - 18.11.2022

Bei etwa jeder zwanzigsten Schwangeren ergibt die Ultraschall-Dopplermessung in der Mitte der Schwangerschaft, dass Gebärmutter und Plazenta nicht ausreichend durchblutet werden. Dann besteht die Gefahr, dass das Kind nicht ausreichend vom mütterlichen Körper versorgt wird und sich nicht zeitgerecht entwickelt.
Astronomie & Weltraum - Physik - 18.11.2022

Numerische Simulation, die die Krümmung der Raumzeit während der Verschmelzung der beiden schwarzen Löcher darstellt.
Forschungsmanagement - Gesundheit - 15.11.2022

Life Preise & Personalia Meldung vom: Zwei Forscher der Friedrich-Schiller-Universität Jena gehören zu den weltweit meistzitierten Wissenschaftlern in ihrem Fachgebiet: der Bioinformatiker Bas E. Dutilh und der Mediziner Andreas Hochhaus.
Biowissenschaften - 10.11.2022
Der blaue Rindenpilz wächst auf Baumstämmen und Ästen von Laubbäumen und zeichnet sich durch seine intensive kobaltblaue Farbe aus. Die Substanzklasse, aus der sich diese blaue Farbe ableitet, ist bei vielen Pilzarten verbreitet. Sie ermöglicht es den Pilzen, bioaktive Stoffe herzustellen, die Totholz abbauen und durch die sie mit ihrem mikrobiellen Umfeld interagieren.
Physik - 07.11.2022

Eine verblüffende Lösung, miteinander verklebte Nano-Bauteile voneinander zu lösen, entwickelten Physiker der Friedrich-Schiller-Universität Jena gemeinsam mit Fachkollegen aus Düsseldorf, Göteborg, Lyngby und Triest. Ihre Idee besteht darin, die Nano-Bauteile in ein Lösungsmittel zu tauchen, das sich in der Nähe eines kritischen Punktes befindet.
Wirtschaft - Politik - 02.11.2022

Vor allem die Einwohnerinnen und Einwohner wirtschaftlich abgehängter Orte und Regionen wählen rechtspopulistische Parteien - so eine gängige These, die die Wahlerfolge von AfD & Co. in Europa erklärt. Ein Forschungsteam der Friedrich-Schiller-Universität Jena hat nun herausgefunden, dass hohe Stimmanteile der AfD in den letzten beiden Bundestagswahlen offenbar mit einem langfristigen Rückgang des relativen Wohlstands einer Region zu erklären sind.










